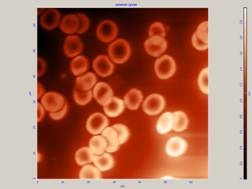
C:\Documents

(студент), (студент), (студент)
ИССЛЕДОВАНИЕ КЛЕТОК КРОВИ ЧЕЛОВЕКА МЕТОДОМ АТОМНО-СИЛОВОЙ МИКРОСКОПИИ
г. Ульяновск, Центр нанотехнологий и материалов (ЦНТИМ), Ульяновский Государственный Университет
ВВЕДЕНИЕ
За последние 10 лет сканирующая зондовая микроскопия превратилась из экзотической методики, доступной лишь ограниченному числу исследовательских групп, в широко распространенный и успешно применяемый инструмент для исследования свойств поверхности [21].
Атомно-силовой микроскоп (АСМ) производит сканирование поверхности на основе принципа поддержания на постоянном нанометровом расстоянии от объекта алмазной иглы, которая притягивается к поверхности за счет межмолекулярных сил. АСМ позволяет исследовать биологические объекты и измерять параметры клеток. В ближайшее время этот метод будет наиболее распространенным в биологических исследованиях. Привлекает возможность исследования объектов не только на нанометровом расстоянии, но и возможность прижизненного исследования клеток [5].
Данная работа посвящена исследованию клеток крови – лейкоцитов и эритроцитов методом атомно-силовой микроскопии. Несмотря на огромное разнообразие методов диагностики клеток крови, атомно-силовая микроскопия представляет собой самый современный инструмент для проведения исследований. АСМ позволяет измерять не только профиль поверхности, но и локальные силы трения, величину адгезии, упругие и вязкие свойства поверхности с субнанометровым пространственным разрешением. Приготовление препаратов для исследований с помощью атомно-силовой микроскопии позволяет избежать жесткой фиксации образцов и методов обработки солями тяжелых металлов, которые традиционно применяются в световой и электронной микроскопии. Подобные процедуры зачастую не соответствуют природным условиям, в которых макромолекулы проявляют свою биологическую активность. Высокое разрешение порядка нескольких нанометров, относительно небольшое время – минуты, которое требуется для сканирования, отсутствие необходимости вводить метки и фиксировать образец делают АСМ одним из удобных инструментов исследований в биологии.
Задачей настоящего исследования явилось выявление наиболее адекватного способа приготовления клеток крови человека для АСМ-анализа структурно-функциональных и вязко-упругих свойств поверхностной мембраны эритроцитов и лейкоцитов.
МАТЕРИАЛ И МЕТОДИКА
Периферическую кровь из локтевой вены (v. mediana cubiti) 1:1 разбавляли раствором Хенкса. В специальные центрифужные пробирки пипеткой наслаивали градиентный раствор фиколл-верографина, затем осторожно наслаивали кровь. После 45 минут центрифугирования, в пробирке образуется четыре фракции: первая (нижняя) – осадок эритроцитов и мертвых клеток, вторая – раствор фиколл-верографина, третья – кольцо лейкоцитов, четвертая – плазма крови. Кольцо, содержащее лейкоциты, осторожно снимали, переносили в чистую пробирку, отмывали в растворе Хенкса. Суспензию лейкоцитов пипетировали и раскапывали (размер капли 20 мкл) на чистые обезжиренные предметные стекла (размер стекол 1х2,5 см) и проводили адгезию при температуре 37 градусов в течение 60 минут. Суспензию эритроцитов наносили на стекло методом мазка и высушивали на воздухе [7].
В качестве фиксаторов использовали следующие вещества: пары формалина (45 минут), метанол (1-10 минут), 2,5% глютаровый альдегид (1-10 минут).
Препараты окрашивали по Романовскому-Гимза для оценки локализации клеток на препарате.
Для исследования поверхности клеток использовали сканирующий зондовый микроскоп Solver Smena A (ЦНТИМ). Сканирование поверхности фиксированных препаратов проводили в полуконтактном режиме на воздухе. Использовались неконтактные кремниевые зонды серии NSG10 (NT-MDT) с жесткостью 5,5 Н/м, резонансной частотой приблизительно 150 кГц, радиусом закругления 10 нм, высота зонда 10-20 мкм. Было проведено сканирование в воздушной фазе более чем 30 образцов. Обработку полученных изображений проводили с помощью программного обеспечения Nova [2,3].
РЕЗУЛЬТАТЫ И ОБСУЖДЕНИЕ
В результате проведенного исследования фиксации клеток крови эритроцитов и лейкоцитов такими фиксаторами, как метанол, 2,5% глютаровый альдегид было получено:
На препаратах лейкоцитов без адгезии, высушенных на воздухе клетки оказываются вздутыми, что свидетельствует о нарушении целостности плазматической мембраны. Данный факт не позволяет определять морфологию и измерять параметры мембраны, возможен лишь подсчёт плотности и количества клеток на препарате (рис. 1). При фиксации лейкоцитов метиловым спиртом необходимо соблюдать определённое время фиксации. При фиксации в течение 10 мин – клетки разрушаются, происходит плазмолиз. При фиксации в течение 1-5 мин - морфология клетки сохраняется. При фиксации лейкоцитов 2,5% глютаровым альдегидом в течение 10 мин – клетки разрушаются, в течение 1-5 мин при соблюдении адгезии и предварительной фиксации в парах формалина клетки сохраняют воду и их АСМ-изображение идентично изображению нативного лимфоцита, в котором четко определены границы клетки. Таким образом, последний способ фиксации лейкоцитов является наиболее оптимальным и дает возможность определения морфологических параметров (рис. 2) [1].

Рис.1. Лейкоциты, высушенные на воздухе. На мембране лейкоцитов возникают вздутия, происходит искажения клеточной поверхности.

Рис.2 Изображение лейкоцита, фиксированного 2,5% глютаровым альдегидом (1-5 мин), при соблюдении адгезии и предварительной фиксации в парах формалина. Проводилось измерение линейных параметров лимфоцита. Справа – силовая кривая, вершина графика соответствует максимальной высоте клетки (высота ядра, т. к. клетка распластана). По силовой кривой можно рассчитать вязко-упругие свойства мембраны изучаемой клетки.
Препараты эритроцитов, высушенных на воздухе, дают адекватную картину распределения клеток в мазке. Скан эритроцитов соответствует их нативному изображению. Такие клетки наиболее удобны для изучения морфологии и параметров мембраны (рис. 3).
Эритроциты, фиксированные метанолом в течение 1-10 мин, имеют искаженную форму. Они слипаются, образуя «столбики». При данном методе фиксации возможен лишь подсчет количества эритроцитов и определение плотности клеток на препарате (рис. 4) [1].
Рис.3 Эритроциты, высушенные на воздухе. Искажение формы клетки не происходит.

Рис.4 Эритроциты при фиксации метанолом. Форма клеток искажена.
В ходе данного исследования были выявлены также артефакты сканирования, которые необходимо учитывать при изучении экспериментального материала. Все наблюдаемые артефакты можно разделить на две основные группы:
1. Особенности, связанные с приготовлением биологического материала:
А) нарушение целостности мембраны (изменение pH, несоблюдение времени фиксации клеток, нарушение температурного режима, механики опыта и др.);
Б) обезвоживание клеток – выход воды из клетки, эритроциты имеют вид теней (высокая концентрация фиксирующего раствора, несоблюдение времени фиксации) (рис. 5);

Рис.5 Обезвоженные клетки. На АСМ-скане видны «тени» клеток вследствие выхода из них воды.
В) неправильная форма клеток в отсутствии у них адгезии;
2. Особенности, связанные с взаимодействием зонда и мембраны клетки:
А) возбуждение зонда на поверхности клеток при резких перепадах высот;
Б) разрыхление мембраны и появление на ней участков, взаимодействующих с зондом (к которым зонд липнет) (рис. 6).
Рис.6 Взаимодействие зонда с мембраной эритроцита, приводящее к разрыхлению мембраны.
ЗАКЛЮЧЕНИЕ
Нами проведена оценка морфологических особенностей клеток крови человека с помощью метода атомно-силовой микроскопии.
При проведении исследований биологических объектов – клеток, методами АСМ возникает ряд проблем, связанных с процедурой приготовления препаратов. Поэтому, прежде чем проводить измерения исследуемых клеток крови необходимо стандартизировать методику получения и приготовления лейкоцитов и эритроцитов.
Для получения устойчивых изображений необходимо правильно иммобилизировать клетки [5]. При исследовании, например, лейкоцитов возникают сложности с их относительно большими вертикальными размерами. В связи с этим, при подготовке препарата важным методическим аспектом является правильный выбор времени инкубации клеток. Чем продолжительнее срок инкубации, тем более распластанными на подложке оказываются клетки и тем удобнее их исследовать. Кроме этого важно правильно выбрать фиксатор и время фиксации клеток, так как лейкоциты неустойчивы, поэтому при передержке в фиксаторе, при высокой его концентрации мембрана клетки и сами лейкоциты разрушаются [6]. Таким образом наиболее оптимальным вариантом подготовки лейкоцитов для изучения на АСМ является: выделение фракций лейкоцитов с помощью фиколл-верографина, адгезия лейкоцитов на стеклянной подложке при температуре 37 градусов в течение 60 мин, фиксации в 2,5% глютаровом альдегиде в течение 1-4 мин, при предварительной фиксации в парах формалина в течение 45 мин.
При изучении эритроцитов наилучшим способом оказалось приготовление препарата методом мазка, при высушивании его на воздухе. Такой способ дает более адекватную картину размещения клеток на препарате. При большем приближении зонда и использовании фильтра «карта латеральных сил» возможна оценка цитоскелета эритроцита, в 3D изображении – оценка особенностей мембраны клетки.
При проведении сканирования изучаемых клеток также необходимо учитывать особенности сканирования. Это в дальнейшем позволит получать более достоверные данные при подсчетах и оценках параметров клеток.
В результате проведенного нами исследования разработан наиболее адекватный способ приготовления клеток крови эритроцитов и лейкоцитов для дальнейшего исследования структурно-функциональных и вязко-упругих свойств поверхностной мембраны клеток крови в норме и при патологии.
СПИСОК ЛИТЕРАТУРЫ
1. Атлас клеток крови и костного мозга. (Под редакцией профессора ). М.: Триада-Х, 19с.
2. Интернет-сайт компании "НТ-МДТ": http://www. *****/
3. Интернет-сайт учебно-научного центра "Бионаноскопия": http://www. nanoscopy. org/Саватеев, M. Н., Kозловская, Н. В., Mойсенович, AIP Conference. – М.: M. M. et al, 2003. – 428 с.
4. Российское общество сканирующей зондовой микроскопии и нанотехнологий: http://www. nanoworld. org
5. , , Лускинович зондовая микроскопия и медико-биологическая нанотехнология: история и перспективы // Передовые статьи№ 5. – С. 9-13.
6. , , Гущина метода сканирующей зондовой микроскопии для исследования морфологических параметров нейтрофильных гранулоцитов // Морфология. – 2005. – Т. 122. - № 1. – С. 60-62.
7. , , // Лабораторное дело№8. - С. 68 .



